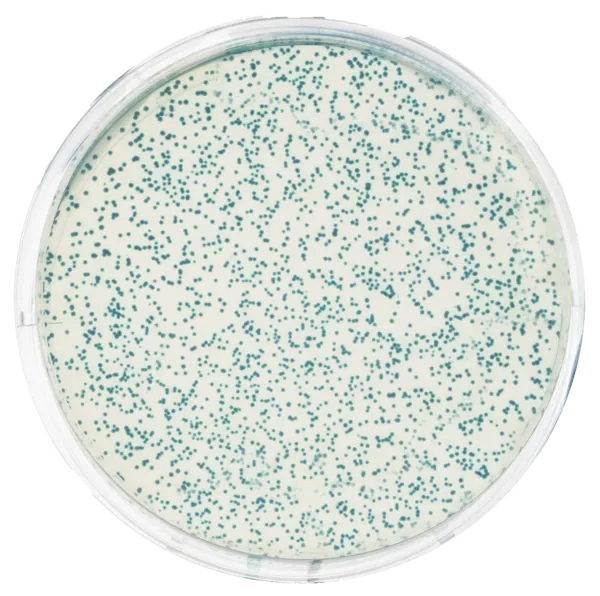
Transformation af E.coli med pGAL  (778221)
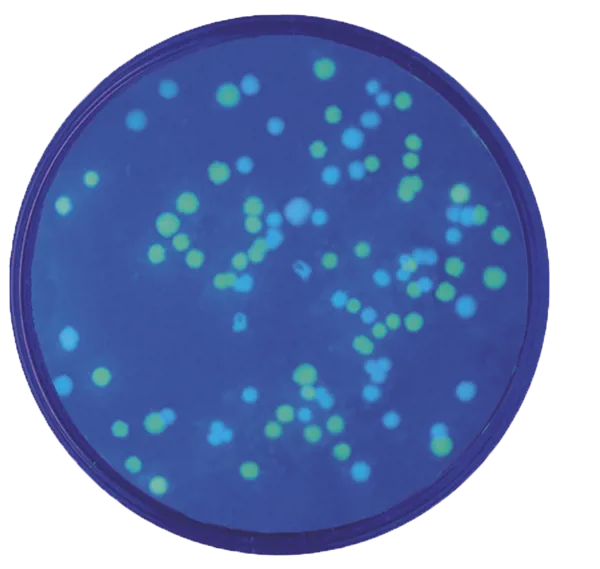
Transformation af E.coli med plasmider  (778222)

Varenr. 287110
UV-lampe, batteridrevet
40,00 DKKEksl. moms




Varenr. 778223
Dette sjove forsøg fra Edvotek (kit nr. 223) giver eleverne mulighed for at fremstille genetisk modificerede mikroorganismer ved at transformere E. coli med genet for grønt fluorescerende protein (pFluoroGreen) fra goplen Aequorea victoria. De transformerede bakterieceller bliver grønne i almindeligt lys og udviser tydelig fluorescens under UV-belysning. Transformationen verificeres ved selektion på LB-agar tilsat ampicillin.
Kittet er velegnet til undervisning på gymnasieniveau og rækker til 10 elevgrupper.
Den samlede forsøgsvarighed er cirka 65 minutter fordelt over to dage: udpladning tager ca. 50 minutter, efterfulgt af inkubation natten over og resultatopgørelse på ca. 15 minutter.
Kittet leveres med alle nødvendige reagenser og prøvematerialer. Følgende udstyr skal være tilgængeligt for at gennemføre forsøget (købes separat): inkubator ved 37 °C, to vandbade, mikropipetter med spidser, termometer, is til isbad, markeringspen, mikroovn (eller alternativt bunsenbrænder eller kogeplade), varmebeskyttende handsker samt UV-lampe med langbølget lys.
Ønsker du at arbejde med spektrofotometrisk bestemmelse angives følgende data fra Edvotek: Excitation peak: 473 nm Emission peak: 509 nm
Hent den opdaterede engelske vejledning på Edvoteks hjemmeside. Linket findes i æsken leveret med kittet.
Bemærk, at anvendelse af dette kit i undervisningen er underlagt særlige lovkrav.
Brugen af dette kit til undervisningsbrug skal varetages af en gymnasielærer, der har gennemgået et kompetencegivende kursus af 2 dages varighed. Kurset omfatter arbejde med mikrobiologiske arbejdsmetoder, herunder sterilteknik og genteknologiske undersøgelsesmetoder, undervisning i god laboratoirepraksis samt affaldshåndtering.
Kurset udbydes af FaDB jf. https://biofag.dk/?page_id=2
Senest to uger før udførelsen af eksprimenter med genteknologisk modificerede organismer indberettes det planlagte eksperiment til fagkonsulent via fællespostkassen [email protected]. Skema til indberetning består af en forside (bilag 6) og en bilagsdel (bilag 1-4). Skema til indberetning af eksperimenter findes på Børne- og Undervisningsministeriets hjemmeside på https://www.uvm.dk/gymnasiale-uddannelser/fag-og-laereplaner/stx-laereplaner under bioteknologi.
De godkendte forsøg fremgår af bilagene til indberetningsskemaet, se aftalens bilag 1-4 jf. Indberetningsskema – bilag (pdf) på https://www.uvm.dk/gymnasiale-uddannelser/fag-og-laereplaner/stx-laereplaner under bioteknologi.
Anvendelse af produktet
I fag som biologi og bioteknologi giver forsøget eleverne mulighed for at arbejde eksperimentelt med gentransformation og genudtryk, og det understøtter temaer som genteknologi, antibiotikaresistens og regulering af proteinsyntese. Ved at bruge fluorescens som indikator får eleverne direkte visuel feedback på transformationens succes, hvilket styrker deres forståelse for molekylære processer i praksis.
Tilsvarende teknikker anvendes i forskningslaboratorier og i bioteknologiske og medicinske erhverv – for eksempel ved produktion af rekombinante proteiner, udvikling af fluorescerende markører i cellebiologi eller ved opbygning af biosensorer til diagnostik.
Specifikationer
Varenr. 778221
Transformation af E.coli med pGAL
1.270,00 DKKEksl. moms
Varenr. 778222
Transformation af E.coli med plasmider
1.463,00 DKKEksl. moms

Varenr. 778300
Blå/hvid kloning af DNA
1.995,00 DKKEksl. moms

Varenr. 778303
Udforskning af bioteknologien med GFP
1.963,00 DKKEksl. moms

Varenr. 778728
BactoBeads E. coli GFP Host
395,00 DKKEksl. moms